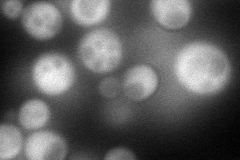
YBR061C
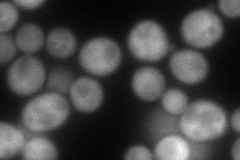
YBR061C
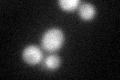
YBR061C
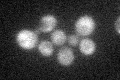
YBR061C
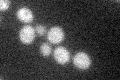
YBR061C

View description
2'-O-ribose methyltransferase, methylates the 2'-O-ribose of nucleotides at positions 32 and 34 of the tRNA anticodon loop
Localization:
Intensity:
Fold change:
Significance:
-
C’ GFP library in SD

cytosol36.48 -
N' NOP1pr-GFP in SD
cytosol113.224 -
N' TEF2pr-mCherry in SD
cytosol103.689 -
N' NATIVEpr-GFP in SD

cytosol36.6761 -
N' TEF2pr-VC and Cyto-VN in SD

#N/A0 -
C’ GFP library in SD+DTT
cytosol33.110.9No -
C’ GFP library in SD+H2O2
cytosol31.710.86No -
C’ GFP library in Starvation Media
cytosol33.630.92No -
C’ GFP library on the background of Pup2-DaMP

cytosol -
C’ GFP library on the background of CCT mutant

cytosol41.27151.13109No
